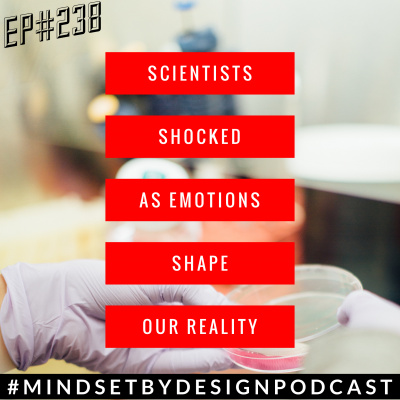
Mindset By Design: Nlp | Self Improvement | Health | Wealth | Happiness. World-class Mind-hacks For Peak Performance

Mindset By Design: Nlp | Self Improvement | Health | Wealth | Happiness. World-class Mind-hacks For Peak Performance
Episode #238: Scientists Shocked as Emotions Shape Our Reality
- Author: Vários
- Narrator: Vários
- Publisher: Podcast
- Duration: 0:34:32
- More information
Informações:
Synopsis
Episode #238: Scientists Shocked as Emotions Shape Our Reality 3 studies show a truth that will blow your mind and change the way you see your business and getting results. This episode will blow your mind. PRESS SUBSCRIBE. WRITE A REVIEW & SHARE WITH 1 PERSON P.S. Whenever You're ready Here are 3 ways I can help you and your business: 1 Personal Mentoring with Andy. (apply for a chat) https://mindsetbydesign.co/coaching 2 NEW FREE TRAINING: Get Any Online Business to Profit Without Changing Anything About It... https://8figurethinker.com 3 Now only $7 Brain Training Audio: https://www.worldclassperformer.co/yes Also check these out :) https://mindsetbydesign.co/business-brain-diagnosis https://www.facebook.com/groups/mbdacademy http://mindsetbydesign.co/testimonials Listen, Subscribe and Pls Write a Quick Review Itunes https://goo.gl/3QfHqU Stitcher https://goo.gl/Xkdzi8 Spotify https://spoti.fi/2END4zI Libsyn https://bit.ly/2VFJExY Youtube https://youtu.be/UbACPiwiVrQ Sound Cloud ht